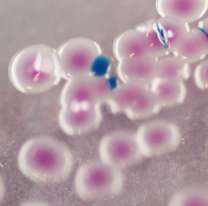

Se enojó porque sus nietas "no lo iban a ver" y les dejó menos de una cuarta parte de su fortuna
Se trata de Frederick Ward, un exsoldado británico que murió en el 2020 y que provocó una disputa familiar que terminó en un juicio.
En general, despedir a un ser querido suele ser un momento complicado para cualquier familia. No sólo por la angustia y la ausencia, sino por los problemas legales que pueden llegar a surgir si hay una herencia de por medio.
Este fue el caso de una familia británica que terminó en la Justicia después de que se enteraran de que el abuelo no les dejó su fortuna porque estaba "decepcionado" ya que "nunca lo iban a visitar".
Frederick Ward tenía 91 años, era exsoldado y padre de tres hijos, aunque uno de ellos ya había fallecido. Dentro de su patrimonio, contaba con más de un millón de euros, que incluían una propiedad. Sin embargo, a las nietas que no lo fueron a visitar en sus últimos días, decidió dejarles tan solo 58 euros.
En este sentido, cuando se realizó la repartición de bienes tras la muerte del hombre, las hermanas Carol Gowing, Angela St Marseille, Amanda Higginbotham, Christine Ward y Janet Pett decidieron presentar una denuncia para reclamar lo que, según ellas, les correspondía. Su argumento se basaba en que una tercera parte de la herencia les pertenecía porque su papá había muerto, por lo cual ese dinero sería para ellas por lazo de sangre.
Pese al intento, el juez del Tribunal Superior, James Brightwell, dictaminó que el testamento, redactado en 2018, era "completamente racional", dado que las mujeres habían tenido un "contacto muy limitado" con su abuelo.
"Algunos pueden opinar que, por lo general, cuando el hijo de un testador ha fallecido antes que él, debe dejar una parte igual a la descendencia de ese hijo. Sin embargo, difícilmente se puede decir que la decisión de no hacerlo y dividir el resto del patrimonio entre sus hijos supervivientes, sea una disposición que ningún testador razonable podría tomar", explicó el magistrado.
Las hermanas que presentaron la denuncia no estuvieron de acuerdo con el dictamen y afirmaron que el testamento era "inválido", alegando que sus tíos habían "influido indebidamente" en su abuelo para que cambiara el documento y no les dejara nada a ellas.
A pesar de ello, el juez no encontró pruebas de que Frederick Ward haya sido "coaccionado" para tomar tal decisión. Finalmente, el caso se cerró y las denunciantes recibieron un sobre con un poco más de 50 euros en efectivo para cada una.

Comentarios